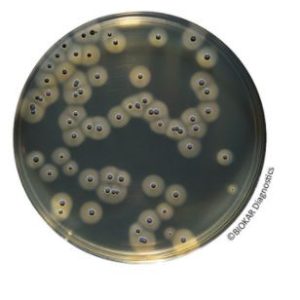
BAIRD-PARKER RPF AGAR

BAIRD-PARKER RPF Agar
$0.00
Manufacturer: Biokar Diagnostics
CAT NO: BT01008
- Description
- Size Guide
- Vendor Info
- More Products
Description
BAIRD-PARKER RPF AGAR
Product Description of BAIRD-PARKER RPF AGAR
Baird Parker RPF (RPF = Rabbit Plasma Fibrinogen) Agar is used for the direct detection and enumeration of coagulase positive staphylococci. The medium has the advantage of considerably reducing the number of confirmation tests for the presence of coagulase positive staphylococci particularly when atypical colonies are observed on other selective media. The medium allows the simultaneous enumeration and confirmation to be performed in a single operation.
PACKAGING
Ready-to-use medium :
BM06708 – 20 Petri plates Ø 90 mm
BM15908 – 20 Petri plates Ø 55 mm
KIT :
BT00508 – 6 vials of 90 mL of base media and 6 RPF freeze-dried supplements
BT01008 – 6 vials of 190 mL of base media and 6 RPF freeze-dried supplements (BS075)
Dehydrated base medium :
BK055HA – 500 g bottle
BK055GC – 5 kg drum
Rabbit Plasma Fibrinogen Supplement :
BS03408 – 8 vials qsp 100 mL
BS03808 – 1 vial qsp 500 mL